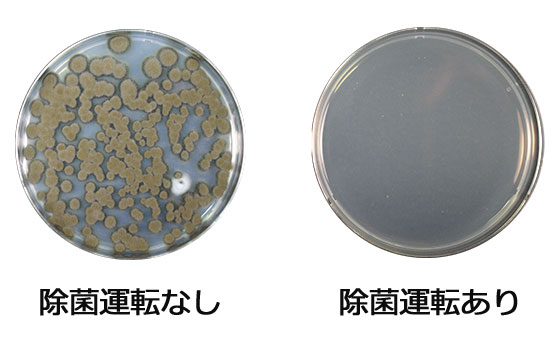

新入荷
再入荷
製品 & サービス | エアコン | 2018年モデル | 「ノクリア」 X
 タイムセール
タイムセール
終了まで
00
00
00
999円以上お買上げで送料無料(※)
999円以上お買上げで代引き手数料無料
999円以上お買上げで代引き手数料無料
通販と店舗では販売価格や税表示が異なる場合がございます。また店頭ではすでに品切れの場合もございます。予めご了承ください。
商品詳細情報
| 管理番号 |
新品 :3755488015
中古 :3755488015-1 |
メーカー | c25b6cb | 発売日 | 2025-04-30 20:12 | 定価 | 35000円 | ||
|---|---|---|---|---|---|---|---|---|---|
| カテゴリ | |||||||||

![三菱電機 MSZ-S2222-W [エアコン(6畳・単相100V)霧ヶ峰 Sシリーズ パールホワイト] 2022年製 未使用に近い開封品](https://auctions.c.yimg.jp/images.auctions.yahoo.co.jp/image/dr000/auc0503/users/45a9740cb9a414b2a603a160d92f59721dc3c9eb/i-img1200x800-1709971019xw6v64145727.jpg)
![三菱電機 エアコン 霧ヶ峰 Xシリーズ ピュアホワイト MSZ-X2822D-W [おもに10畳用 /100V] 未使用に近い 動作未確認品](https://auctions.c.yimg.jp/images.auctions.yahoo.co.jp/image/dr000/auc0409/users/45a9740cb9a414b2a603a160d92f59721dc3c9eb/i-img1200x800-1693829891drbei7161586.jpg)


![ダイキン DAIKIN エアコン EBKシリーズ ホワイト AN25ZEBKS-W [おもに8畳用 /100V] 未使用に近い 動作未確認品](https://auctions.c.yimg.jp/images.auctions.yahoo.co.jp/image/dr000/auc0409/users/45a9740cb9a414b2a603a160d92f59721dc3c9eb/i-img1200x800-16938014202ukzhd147872.jpg)
![■サンコー プラスチックパレット 816354 TS-097114R4 ライトブルー〔品番:SKTS097114R4BL〕【3481481:0】[送料別途見積り][法人・事業所限定][外直送][店頭受取不可]](https://tshop.r10s.jp/hcvalor-eshop/cabinet/trusco/3481/trusco-3481481.jpg)









